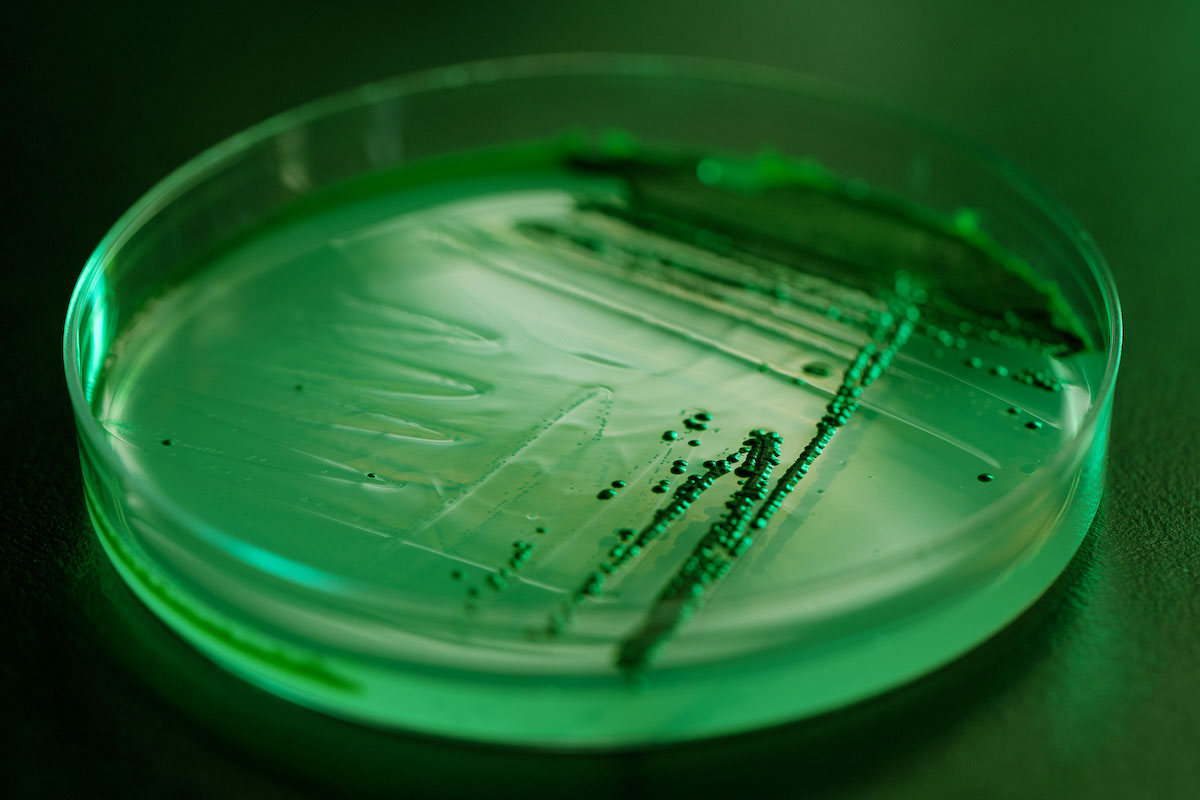

Algae utilize CO2 to grow the biomass that contains the oil, thus recycling CO2. Once the biofuel is burned, CO2 is released again. We aim to minimize the energy required—and to source it as much as possible from renewables—for the entire algal biofuels production process.
The Time to Act
Global population growth and higher living standards continue to increase the need for energy. By 2040, humanity is expected to consume roughly a third more energy than in 2017. As the major source of energy generation, the combustion of fossil fuels has caused dramatic increases in atmospheric CO2 concentrations, air pollution and an acceleration of the rise in global warming.
Against this backdrop, we need to accelerate our transition to renewable, scalable and sustainable energy. We need to slow down and ultimately halt rising atmospheric temperatures and air pollution. At the same time, we need to meet the growing energy needs of a larger and more prosperous global population.
The increasing penetration of renewable technologies like wind and solar for electricity generation is encouraging. Yet in the heavy transportation sector, fuels with much higher energy density than batteries are essential to power planes, ships, long distance heavy trucks, and trains. For that we need renewable and sustainable diesel and jet fuels.
So what can be done to reduce these major sources of CO2 emissions and pollution?
We believe that the answer lies in nature, with the adaptation of microalgae as cell factories producing sustainable and renewable diesel and jetfuel from sunlight and CO2, growing in saltwater where the production does not compete with agriculture or put additional burdens on freshwater consumption.
The Power of Algae
At Synthetic Genomics, we’re harnessing the power of algae to produce biofuels that recycle the atmosphere’s excess amounts of CO2. Microalgae are excellent at converting CO2 and sunlight into biomass, especially when compared to land-based crop plants like oil palm, sugar cane or corn. But there are some challenges that must be worked out before we can use microalgae to make fuel. In their natural form, microalgae, while having impressive productivity, are not economical due to the comparatively high costs of algal farm installations and costs of processing. Productivity and oil yields have to significantly increase before algal biofuels are scalable and cost competitive. Since algae mostly reproduce asexually, traditional plant optimization through cross-breeding is infeasible to impart the needed characteristics into the microalgae.
With advancements in genome sequencing, bioinformatics and precise gene editing technologies, improving algae’s productivity is now becoming a reality. Synthetic Genomics is rapidly progressing towards optimizing algae that are technically capable of large scale oil production that can be refined into renewable diesel and jetfuel.
Sustainability
We are redesigning algae to solve impending global challenges. Providing energy to a growing, more prosperous world—all while being mindful of greenhouse gases—is one of the most important challenges we face for protecting and improving the health of the planet. Having conducted more than a decade of fundamental genomic and algal research, we have reached the inflection point where we see the path to a scalable technology.
We are committed to providing a true solution to the global pollution and climate crisis. Our research has been guided by multiple sustainability principles:
The Science Behind Algae Biofuel
The biofuel derived from algae is oil extracted from accumulated lipids within the cell. Algae can yield more biofuel per acre than plant-based biofuels from sugar cane, palm, or corn. Oil from algae can also potentially be processed in conventional refineries, producing fuels no different from convenient, energy-dense diesel. Oil produced from algae also holds promise as a potential feedstock for chemical manufacturing.
Reaching Commercial Deployment
We have a deep understanding of the biology, genomics and tools needed to optimize algae that can be deployed at scale. However, a solution capable of making positive contributions to CO2 levels, climate change and pollution requires a major partner that can complement our biological expertise with world-class engineering, global deployment and commercialization expertise. Our decade-long partnership with ExxonMobil allows us to achieve exactly that.
We have used the last decade to perfect our understanding of algae, build the necessary genomic tools and forge a path that leads to a solution. In March 2018, ExxonMobil and Synthetic Genomics announced a target of producing 10,000 barrels of algal biofuel per day by 2025. To accomplish our goal, we are currently working at our California Advanced Algal Facility (CAAF) in the Imperial Valley desert to pilot test and optimize production conditions, complementing the research we do at our facility in La Jolla, CA .
Beyond Biofuels
The combination of our deep-rooted scientific, genomic and algal optimization experience, intellectual property and ability to integrate from the lab to the pond at our California Advanced Algal Facility (CAAF) allows us to solve global challenges using algae’s unique properties beyond biofuels. We see multiple potential opportunities: